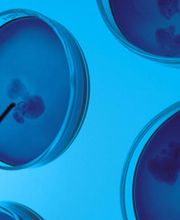
inmunoensayos1.jpg

Asesoría integral higiénico-sanitario. APPCC, IFS.
Itsas Natura
Laboratorio
0.0(0 Reseñas)
Bidea Astigarragako, 2, 6ª Planta Local 1, 20180 Ugaldetxo
+34943260537 (Teléfono)
Noticias y Ofertas
Información
Año de fundación
1992
1992
Horario de apertura
- Lunes
- 08:30 a 18:30
- Martes
- 08:30 a 18:30
- Miércoles
- 08:30 a 18:30
- Jueves
- 08:30 a 18:30
- Viernes
- 08:30 a 18:30
- Sábado
- Cerrado
- Domingo
- Cerrado
Industrias / Especializaciones
LaboratorioMedios

Mapa
Bidea Astigarragako, 2, 6ª Planta Local 1, 20180 Ugaldetxo
Reseñas
Reseñas no verificadas0.0
(0 Reseñas)